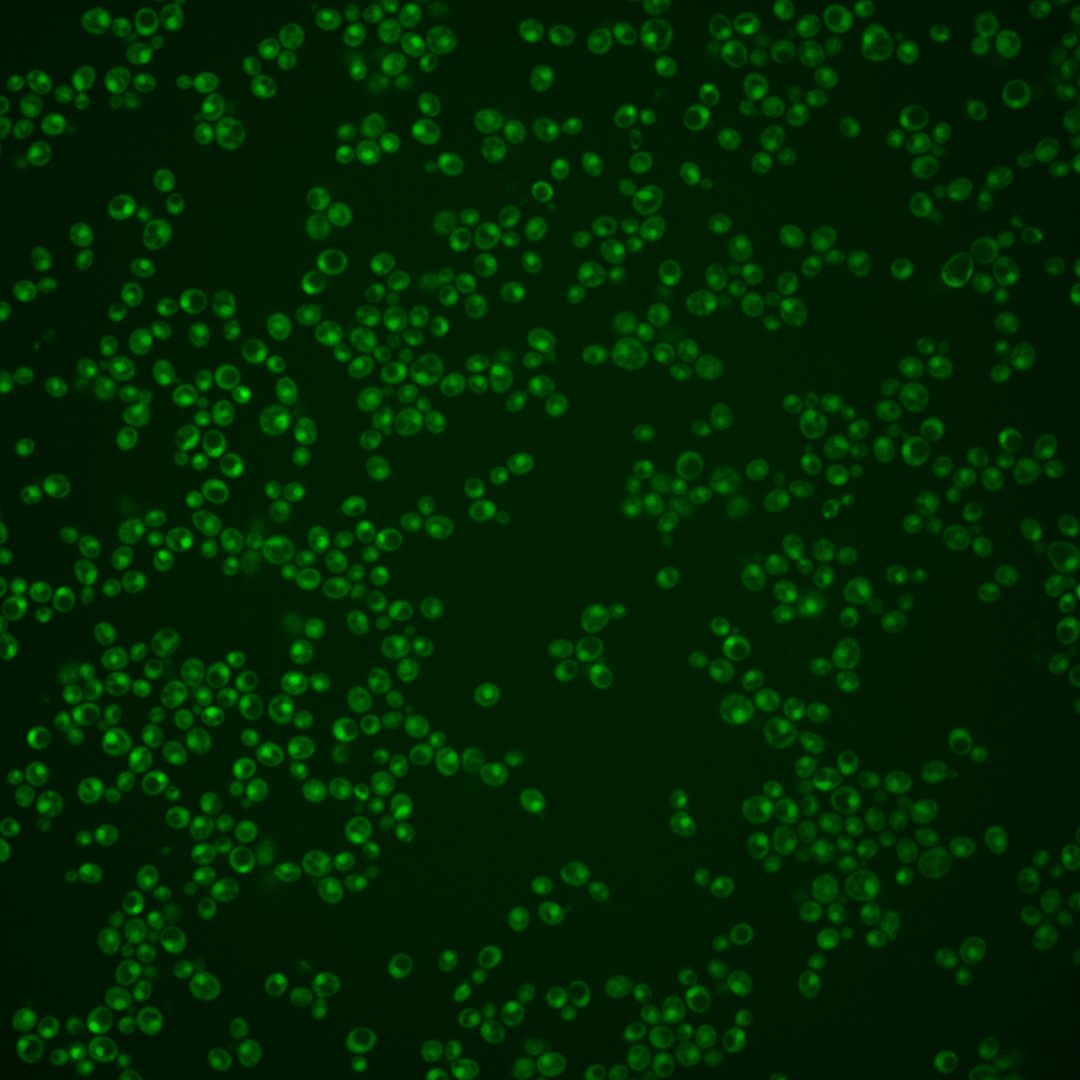
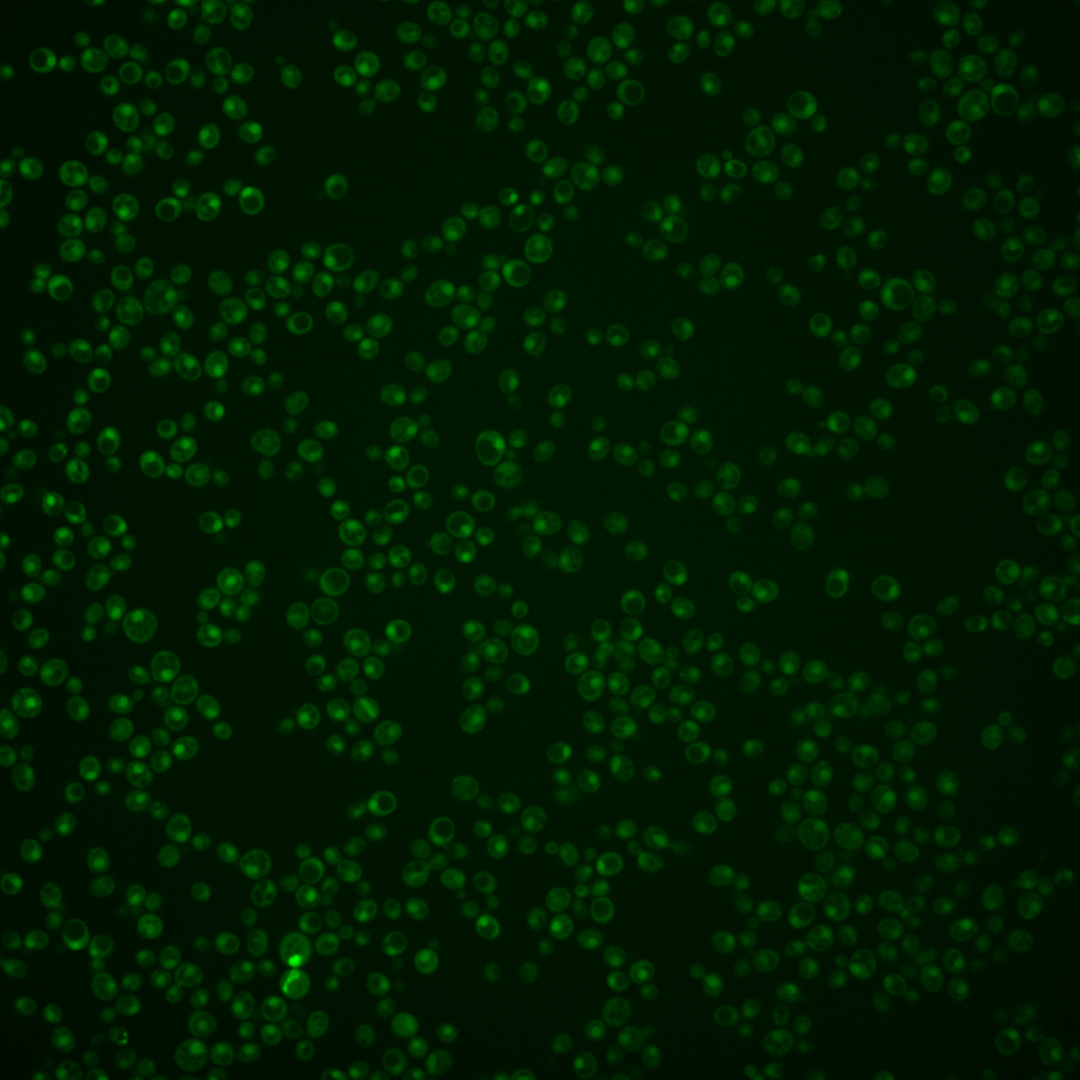
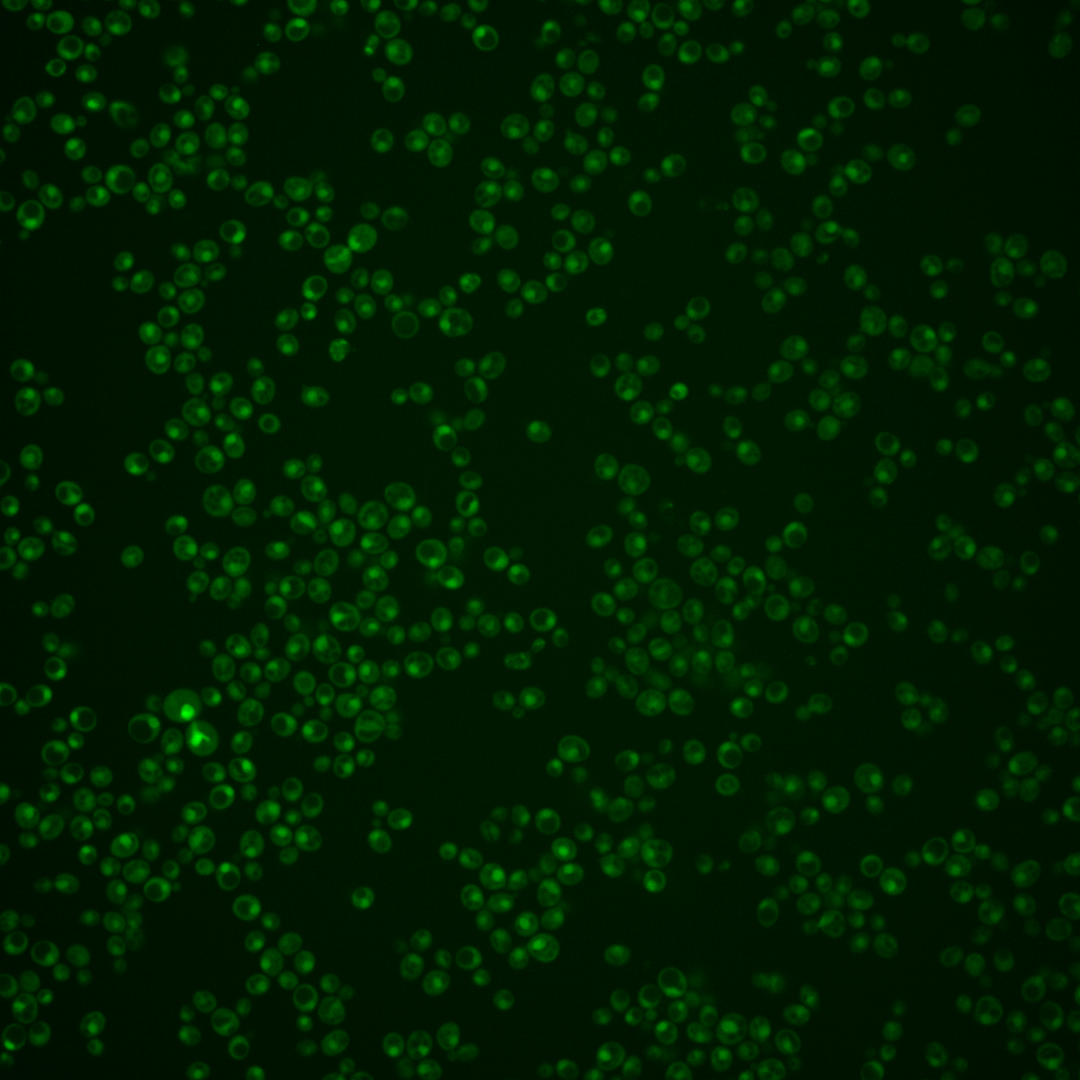

| Standard name | |
|---|---|
| Human Ortholog | |
| Description | cAMP-dependent protein kinase catalytic subunit; promotes vegetative growth in response to nutrients via the Ras-cAMP signaling pathway; partially redundant with Tpk1p and Tpk3p; localizes to P-bodies during stationary phase; relocalizes to the cytosol in response to hypoxia |
Micrographs




















































































Sub-cellular Localization
Yeast GFP Assignment
Protein Abundance
Localization Change
External localization resources
| ensLOC | DeepLoc | |||||||||||||||||||||||
|---|---|---|---|---|---|---|---|---|---|---|---|---|---|---|---|---|---|---|---|---|---|---|---|---|
| Localization | WT1 | WT2 | WT3 | RAP60 | RAP140 | RAP220 | RAP300 | RAP380 | RAP460 | RAP540 | RAP620 | RAP700 | HU80 | HU120 | HU160 | rpd3Δ_1 | rpd3Δ_2 | rpd3Δ_3 | WT1 | WT2 | WT3 | AF100 | AF140 | AF180 |
| Cortical Patches | 0 | 0 | 0 | 0 | 0 | 0 | 0 | 0 | 1 | 0 | 0 | 0 | 0 | 0 | 0 | 0 | 0 | 0 | 0 | 0 | 2 | 0 | 1 | 1 |
| Bud | 0 | 1 | 0 | 2 | 4 | 11 | 12 | 11 | 11 | 19 | 9 | 17 | 1 | 1 | 0 | 0 | 0 | 0 | 6 | 7 | 4 | 13 | 27 | 25 |
| Bud Neck | 0 | 0 | 0 | 0 | 0 | 0 | 0 | 0 | 0 | 0 | 0 | 0 | 0 | 0 | 0 | 0 | 0 | 0 | 0 | 0 | 0 | 3 | 5 | 3 |
| Bud Site | 0 | 0 | 0 | 1 | 0 | 3 | 7 | 5 | 11 | 13 | 15 | 20 | 0 | 0 | 0 | 0 | 0 | 0 | – | – | – | – | – | – |
| Cell Periphery | 0 | 0 | 0 | 0 | 0 | 0 | 0 | 0 | 1 | 1 | 1 | 1 | 1 | 0 | 1 | 1 | 0 | 0 | 0 | 0 | 0 | 0 | 0 | 0 |
| Cytoplasm | 16 | 20 | 41 | 41 | 66 | 110 | 89 | 80 | 75 | 90 | 70 | 96 | 47 | 101 | 125 | 7 | 18 | 16 | 9 | 13 | 19 | 36 | 41 | 18 |
| Endoplasmic Reticulum | 0 | 1 | 0 | 1 | 0 | 0 | 0 | 2 | 0 | 0 | 0 | 1 | 2 | 1 | 1 | 2 | 4 | 1 | 0 | 0 | 0 | 1 | 4 | 5 |
| Endosome | 1 | 4 | 4 | 3 | 20 | 17 | 3 | 5 | 4 | 25 | 0 | 1 | 6 | 25 | 7 | 3 | 1 | 0 | 4 | 4 | 7 | 5 | 7 | 10 |
| Golgi | 0 | 0 | 0 | 0 | 0 | 0 | 0 | 0 | 0 | 0 | 0 | 0 | 1 | 1 | 1 | 0 | 1 | 0 | 0 | 1 | 2 | 0 | 1 | 3 |
| Mitochondria | 6 | 13 | 94 | 102 | 98 | 283 | 377 | 356 | 327 | 361 | 322 | 597 | 3 | 3 | 3 | 5 | 5 | 1 | 2 | 2 | 4 | 4 | 6 | 15 |
| Nucleus | 256 | 315 | 305 | 229 | 296 | 282 | 363 | 348 | 301 | 319 | 279 | 402 | 338 | 340 | 306 | 58 | 77 | 61 | 307 | 356 | 354 | 244 | 301 | 277 |
| Nuclear Periphery | 0 | 0 | 0 | 3 | 1 | 0 | 3 | 2 | 4 | 2 | 2 | 2 | 0 | 0 | 0 | 0 | 0 | 0 | 0 | 0 | 1 | 1 | 1 | 2 |
| Nucleolus | 0 | 0 | 0 | 0 | 1 | 3 | 31 | 61 | 16 | 17 | 13 | 34 | 0 | 5 | 2 | 0 | 2 | 1 | 5 | 9 | 3 | 9 | 12 | 19 |
| Peroxisomes | 0 | 0 | 0 | 0 | 0 | 0 | 0 | 0 | 0 | 0 | 0 | 0 | 0 | 0 | 1 | 0 | 0 | 0 | 0 | 0 | 0 | 0 | 0 | 0 |
| SpindlePole | 1 | 0 | 0 | 1 | 1 | 0 | 0 | 1 | 1 | 0 | 0 | 0 | 0 | 0 | 1 | 0 | 0 | 0 | 8 | 8 | 10 | 8 | 22 | 12 |
| Vac/Vac Membrane | 60 | 83 | 35 | 23 | 115 | 104 | 154 | 132 | 119 | 116 | 69 | 103 | 111 | 165 | 143 | 19 | 31 | 24 | 23 | 27 | 50 | 78 | 109 | 107 |
| Unique Cell Count | 313 | 403 | 422 | 352 | 515 | 626 | 840 | 791 | 666 | 756 | 591 | 984 | 473 | 591 | 566 | 85 | 126 | 99 | 372 | 436 | 472 | 413 | 550 | 511 |
| Labelled Cell Count | 340 | 437 | 479 | 406 | 602 | 813 | 1039 | 1003 | 871 | 963 | 780 | 1274 | 510 | 642 | 591 | 95 | 139 | 104 | 372 | 436 | 472 | 413 | 550 | 511 |
Yeast GFP Assignment
Protein Abundance
| Screen | WT1 | WT2 | WT3 | RAP60 | RAP140 | RAP220 | RAP300 | RAP380 | RAP460 | RAP540 | RAP620 | RAP700 | HU80 | HU120 | HU160 | rpd3Δ_1 | rpd3Δ_2 | rpd3Δ_3 | AF100 | AF140 | AF180 |
|---|---|---|---|---|---|---|---|---|---|---|---|---|---|---|---|---|---|---|---|---|---|
| Mean Cell GFP Intensity (1e-4) | 6.9 | 6.6 | 4.7 | 4.7 | 5.2 | 5.0 | 5.0 | 5.2 | 5.3 | 5.0 | 5.1 | 5.1 | 7.7 | 7.9 | 8.7 | 10.6 | 10.3 | 10.5 | 7.5 | 7.5 | 8.0 |
| Std Deviation (1e-4) | 1.5 | 0.9 | 0.8 | 1.1 | 1.2 | 1.0 | 1.2 | 1.4 | 1.3 | 1.2 | 1.3 | 1.2 | 1.5 | 1.6 | 1.8 | 1.9 | 2.0 | 2.1 | 1.7 | 1.8 | 1.8 |
| Intensity Change (Log2) | – | – | – | -0.01 | 0.13 | 0.09 | 0.09 | 0.16 | 0.18 | 0.1 | 0.11 | 0.13 | 0.72 | 0.74 | 0.89 | 1.17 | 1.13 | 1.16 | 0.68 | 0.68 | 0.77 |
Localization Change
| Localization | RAP60 | RAP140 | RAP220 | RAP300 | RAP380 | RAP460 | RAP540 | RAP620 | RAP700 | HU80 | HU120 | HU160 | rpd3Δ_1 | rpd3Δ_2 | rpd3Δ_3 |
|---|---|---|---|---|---|---|---|---|---|---|---|---|---|---|---|
| Cortical Patches | 0 | 0 | 0 | 0 | 0 | 0 | 0 | 0 | 0 | 0 | 0 | 0 | 0 | 0 | 0 |
| Bud | 0 | 0 | 0 | 0 | 0 | 0 | 3.3 | 0 | 2.7 | 0 | 0 | 0 | 0 | 0 | 0 |
| Bud Neck | 0 | 0 | 0 | 0 | 0 | 0 | 0 | 0 | 0 | 0 | 0 | 0 | 0 | 0 | 0 |
| Bud Site | 0 | 0 | 0 | 0 | 0 | 0 | 0 | 3.3 | 2.9 | 0 | 0 | 0 | 0 | 0 | 0 |
| Cell Periphery | 0 | 0 | 0 | 0 | 0 | 0 | 0 | 0 | 0 | 0 | 0 | 0 | 0 | 0 | 0 |
| Cytoplasm | 0.9 | 1.5 | 3.6 | 0.5 | 0.2 | 0.8 | 1.1 | 1.1 | 0 | 0.1 | 3.3 | 5.1 | -0.4 | 1.5 | 1.8 |
| Endoplasmic Reticulum | 0 | 0 | 0 | 0 | 0 | 0 | 0 | 0 | 0 | 0 | 0 | 0 | 0 | 0 | 0 |
| Endosome | 0 | 2.8 | 2.0 | 0 | 0 | 0 | 2.5 | 0 | 0 | 0 | 3.1 | 0 | 0 | 0 | 0 |
| Golgi | 0 | 0 | 0 | 0 | 0 | 0 | 0 | 0 | 0 | 0 | 0 | 0 | 0 | 0 | 0 |
| Mitochondria | 0 | -1.2 | 7.6 | 7.8 | 7.8 | 8.9 | 8.6 | 10.3 | 13.2 | -10.4 | -11.6 | -11.4 | -3.5 | -4.7 | -4.9 |
| Nucleus | -2.2 | -4.7 | -8.7 | -9.8 | -9.4 | -8.8 | -9.9 | -8.0 | -10.8 | -0.3 | -4.8 | -5.8 | -0.8 | -2.4 | -2.1 |
| Nuclear Periphery | 0 | 0 | 0 | 0 | 0 | 0 | 0 | 0 | 0 | 0 | 0 | 0 | 0 | 0 | 0 |
| Nucleolus | 0 | 0 | 0 | 4.0 | 5.9 | 3.2 | 3.1 | 3.1 | 3.9 | 0 | 0 | 0 | 0 | 0 | 0 |
| Peroxisomes | 0 | 0 | 0 | 0 | 0 | 0 | 0 | 0 | 0 | 0 | 0 | 0 | 0 | 0 | 0 |
| SpindlePole | 0 | 0 | 0 | 0 | 0 | 0 | 0 | 0 | 0 | 0 | 0 | 0 | 0 | 0 | 0 |
| Vacuole | -0.9 | 5.8 | 3.9 | 4.7 | 4.0 | 4.4 | 3.5 | 1.7 | 1.3 | 6.1 | 7.7 | 6.9 | 3.8 | 4.9 | 4.5 |
External localization resources
Images






























Protein Concentration and Protein Localization Data
| R1 | R2 | R3 | ||||||||||||||||
|---|---|---|---|---|---|---|---|---|---|---|---|---|---|---|---|---|---|---|
| G1 Pre-START | G1 Post-START | S/G2 | Metaphase | Anaphase | Telophase | G1 Pre-START | G1 Post-START | S/G2 | Metaphase | Anaphase | Telophase | G1 Pre-START | G1 Post-START | S/G2 | Metaphase | Anaphase | Telophase | |
| Concentration | 1.8886 | 2.09 | 1.9068 | 1.5563 | 1.3688 | 1.8386 | 4.5575 | 5.1709 | 4.618 | 3.906 | 4.1145 | 4.6854 | 2.0751 | 2.7491 | 2.2162 | 2.2925 | 2.1062 | 2.3305 |
| Actin | 0.0024 | 0.0001 | 0.0061 | 0.014 | 0.0072 | 0.0007 | 0.0043 | 0.0014 | 0.0099 | 0.0007 | 0.0047 | 0.0048 | 0.0002 | 0 | 0 | 0 | 0 | 0 |
| Bud | 0.0007 | 0.0002 | 0.0011 | 0.0002 | 0.0003 | 0.0014 | 0.0004 | 0.0003 | 0.0007 | 0.0001 | 0.0001 | 0.0001 | 0 | 0 | 0 | 0 | 0 | 0 |
| Bud Neck | 0.006 | 0.0006 | 0.0012 | 0.0003 | 0.001 | 0.0017 | 0.0058 | 0.0004 | 0.0009 | 0.0065 | 0.0007 | 0.0017 | 0.0033 | 0.0002 | 0.0001 | 0.0001 | 0.0002 | 0.0009 |
| Bud Periphery | 0.001 | 0.0001 | 0.0007 | 0.0006 | 0.0002 | 0.0005 | 0.0016 | 0.0003 | 0.0018 | 0.0001 | 0.0002 | 0.0001 | 0 | 0 | 0 | 0 | 0 | 0 |
| Bud Site | 0.0095 | 0.0021 | 0.0028 | 0.0007 | 0.0005 | 0.0002 | 0.0018 | 0.0017 | 0.0012 | 0.003 | 0.0004 | 0.0001 | 0.0003 | 0.0001 | 0 | 0 | 0 | 0 |
| Cell Periphery | 0.0006 | 0 | 0.0001 | 0.0001 | 0.0003 | 0 | 0.0004 | 0 | 0.0002 | 0.0001 | 0 | 0 | 0 | 0 | 0 | 0 | 0 | 0 |
| Cytoplasm | 0.0373 | 0.0466 | 0.0254 | 0.0072 | 0.0137 | 0.0189 | 0.0289 | 0.0355 | 0.0142 | 0.01 | 0.0045 | 0.0155 | 0.0217 | 0.0413 | 0.0047 | 0.0034 | 0.0014 | 0.0128 |
| Cytoplasmic Foci | 0.0148 | 0.0005 | 0.0079 | 0.006 | 0.0179 | 0.0008 | 0.0025 | 0.0014 | 0.0036 | 0.0179 | 0.0158 | 0.0008 | 0.0025 | 0.0001 | 0 | 0 | 0 | 0.0002 |
| Eisosomes | 0.0001 | 0 | 0.0001 | 0.0004 | 0.0006 | 0 | 0.0002 | 0 | 0.0001 | 0 | 0 | 0 | 0 | 0 | 0 | 0 | 0 | 0 |
| Endoplasmic Reticulum | 0.004 | 0.0008 | 0.0019 | 0.0006 | 0.0023 | 0.0004 | 0.0026 | 0.001 | 0.0015 | 0.0003 | 0.0012 | 0.0007 | 0.0007 | 0.0008 | 0.0001 | 0 | 0 | 0.0002 |
| Endosome | 0.024 | 0.0009 | 0.0113 | 0.01 | 0.0068 | 0.0016 | 0.0098 | 0.0022 | 0.0076 | 0.0041 | 0.0255 | 0.003 | 0.0042 | 0.0004 | 0.0001 | 0 | 0 | 0.0005 |
| Golgi | 0.0069 | 0 | 0.0044 | 0.008 | 0.0015 | 0.0007 | 0.0021 | 0.0003 | 0.0019 | 0.0011 | 0.003 | 0.0017 | 0.0003 | 0 | 0 | 0 | 0 | 0 |
| Lipid Particles | 0.0091 | 0.0001 | 0.005 | 0.0034 | 0.008 | 0.0011 | 0.0061 | 0.0001 | 0.0026 | 0.0056 | 0.0044 | 0.0005 | 0.0009 | 0 | 0 | 0 | 0 | 0 |
| Mitochondria | 0.007 | 0.0002 | 0.0047 | 0.018 | 0.0055 | 0.0018 | 0.0029 | 0.001 | 0.011 | 0.0004 | 0.0041 | 0.0002 | 0.0002 | 0.0001 | 0.0001 | 0.0001 | 0.0001 | 0.0001 |
| None | 0.017 | 0.0113 | 0.0108 | 0.0025 | 0.0222 | 0.0012 | 0.0047 | 0.0008 | 0.0113 | 0.0011 | 0.0032 | 0.0131 | 0.0082 | 0.0011 | 0.0002 | 0.0001 | 0 | 0.0042 |
| Nuclear Periphery | 0.021 | 0.0147 | 0.0067 | 0.0032 | 0.0154 | 0.0061 | 0.0112 | 0.0085 | 0.0076 | 0.0018 | 0.0086 | 0.0029 | 0.0058 | 0.0151 | 0.0024 | 0.002 | 0.002 | 0.0035 |
| Nucleolus | 0.0083 | 0.0025 | 0.0025 | 0.0028 | 0.0126 | 0.0076 | 0.0031 | 0.0025 | 0.0043 | 0.0062 | 0.0109 | 0.0044 | 0.0024 | 0.0015 | 0.0014 | 0.0012 | 0.0022 | 0.0033 |
| Nucleus | 0.7841 | 0.9055 | 0.8883 | 0.9131 | 0.8629 | 0.9291 | 0.8958 | 0.9354 | 0.9028 | 0.9051 | 0.882 | 0.942 | 0.9406 | 0.9356 | 0.9874 | 0.9899 | 0.9925 | 0.9678 |
| Peroxisomes | 0.0121 | 0 | 0.0059 | 0.0043 | 0.003 | 0.0003 | 0.0026 | 0.0006 | 0.0026 | 0.0276 | 0.0179 | 0.0001 | 0.0002 | 0 | 0 | 0 | 0 | 0 |
| Punctate Nuclear | 0.0248 | 0.0121 | 0.0104 | 0.0029 | 0.0147 | 0.0245 | 0.0073 | 0.0052 | 0.0085 | 0.0025 | 0.0099 | 0.0078 | 0.0079 | 0.0031 | 0.0035 | 0.003 | 0.0015 | 0.006 |
| Vacuole | 0.0075 | 0.0014 | 0.0024 | 0.0009 | 0.0022 | 0.0008 | 0.0031 | 0.0009 | 0.0047 | 0.0055 | 0.0019 | 0.0007 | 0.0005 | 0.0003 | 0.0001 | 0 | 0.0001 | 0.0002 |
| Vacuole Periphery | 0.0017 | 0.0003 | 0.0004 | 0.0007 | 0.0013 | 0.0004 | 0.0028 | 0.0002 | 0.0011 | 0.0001 | 0.0011 | 0.0001 | 0.0001 | 0.0001 | 0 | 0 | 0 | 0.0001 |
Sequencing Data
| R1 | R2 | |||||||||
|---|---|---|---|---|---|---|---|---|---|---|
| G1 Post-START | S/G2 | Metaphase | Anaphase | Telophase | G1 Post-START | S/G2 | Metaphase | Anaphase | Telophase | |
| Gene Expression | 13.9977 | 6.9038 | 10.2458 | 18.2998 | 16.897 | 15.4372 | 15.2696 | 17.0784 | 21.6722 | 16.9367 |
| Translational Efficiency | 0.9302 | 2.0515 | 1.1148 | 0.868 | 0.8303 | 1.385 | 1.291 | 1.2377 | 1.4057 | 1.1292 |
Hit Data
| Dataset | Hit |
|---|---|
| Protein Concentration | ✔ |
| Protein Localization | ✘ |
| Gene Expression | ✘ |
| Translational Efficiency | ✘ |
Endocytosis
| Temp | Actin Patch (Sac6-tdTomato) | Cortical Patch (Sla1-GFP) | Late Endosome (Snf7-GFP) | Vacuole (Vph1-GFP) |
|---|---|---|---|---|
| 37℃ | ||||
| RT |
Cell Cycle Omics
CYCLoPs (Tpk2-GFP)
| Gene / Allele | Actin Patch (Sac6-tdTomato) | Cortical Patch (Sla1-GFP) | Late Endosome (Snf7-GFP) | Vacuole (Sac6-tdTomato) |
|---|
| Gene | Images |
|---|
| Gene | Images |
|---|
Images are not yet available
Images are not yet available